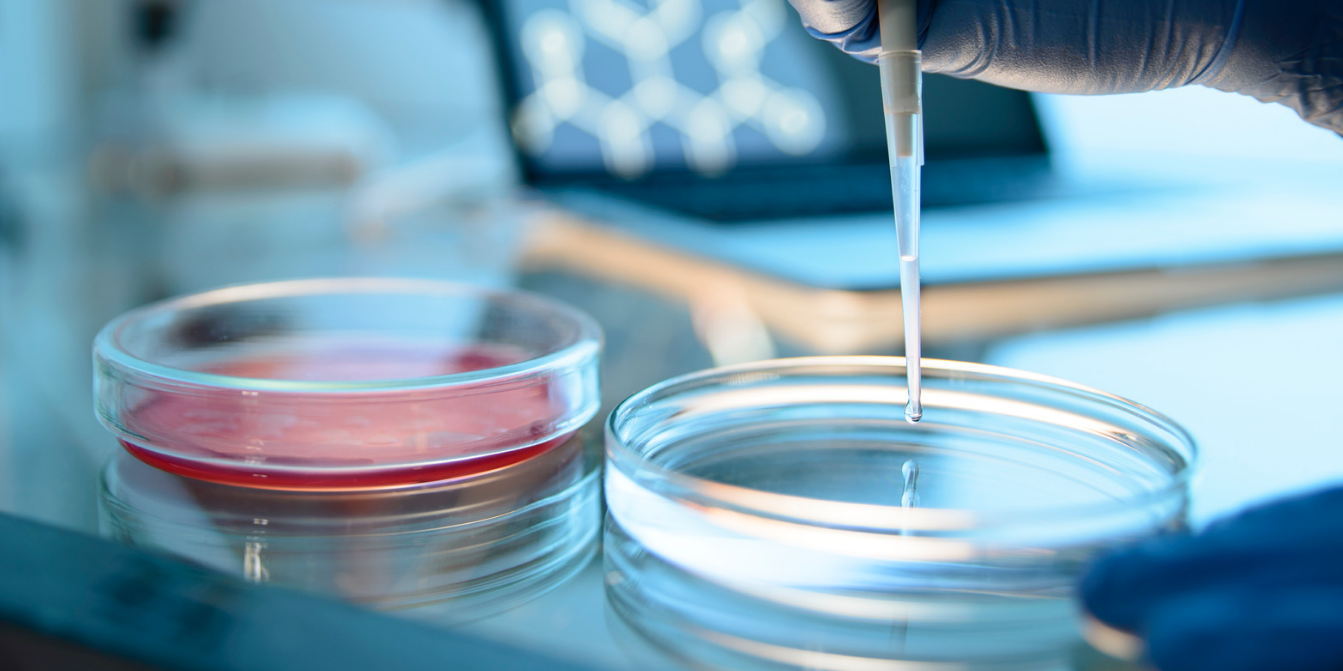
Hera BioLabs-piggyBac-Optimize Stable Cell Line Creation With piggyBac Transposon System

The piggyBac transposase/transposon system is a non-viral gene integration platform designed for use in many different research and commercial applications. Because piggyBac favors integration into stably expressed sites of open chromatin, it enables highly durable gene expression. Combined with a large cargo capacity of over 200kb, piggyBac surpasses many other transposon and viral delivery vehicles, making it the optimal choice for stable cell and animal model creation.
High efficiency and stability of piggyBac transposon integration have been validated across some of the most valuable and widely used genetic systems, including mammalian, yeast, insect, and stem cell models. To date, over 400 peer-reviewed papers have been published utilizing piggyBac transposase technology.
Hera BioLabs provides piggyBac products and licenses, which include research and commercial applications for drug discovery & development, synthetic biology and agriculture.
Features of piggyBac
- Small to enormous gene cargo integration (200kb+)
- Leading transposase efficiency demonstrated across multiple cell types and species
- Stable, high-level expression from integration into open chromatin

Reproducible Results & Downstream Reliability
Long-term transgene stability is essential for creating consistent and reproducible results especially when establishing reporter cell line or expressing recombinant antibodies. The piggyBac transposon genomic integrations are extremely stable for months of continuous culture and >50 passages.
Mossine et al, demonstrated 10-months of continuous culture of their THP-1 reporter cell line creating with piggyBac without gene silencing showing the same response phenotype (blue) as the freshly thawed (green) cells.

Mossine VV, Waters JK, Hannink M, Mawhinney TP (2013) piggyBac Transposon plus Insulators Overcome Epigenetic Silencing to Provide for Stable Signaling Pathway Reporter Cell Lines. PLoS ONE 8(12)

piggyBac as a high-capacity transgenesis and gene-therapy vector in human cells and mice. Rongbo Li, Yuan Zhuang, Min Han, Tian Xu and Xiaohui Wu. Disease Models & Mechanisms (2013)
Flexible, Easier-to-Use Larger DNA Cargo Sizes
Unlike most transposases, piggyBac enables efficient integration of both large and small transgenes. Demonstrated to work efficiently beyond 250kb+ in size including full BAC artificial chromosomes. Super piggyBac is consistently published demonstrating integration of vectors between 10kb and 25kb, including complex multi-component constructs such as ion channels and GPCRs.
The piggyBac fluorescence in situ hybridization (FISH) demonstrates piggyBac-mediated stable integration of a 200kb+ DNA fragment and chromosome locations in mouse ES cells.
Transgenic Animal Models
Transgene integration into embryos using piggyBac, via pronuclear injection (PNI) or embryonic stem (ES) cell modification, enables highly efficient generation of transgenic animal models. In vivo delivery of piggyBac enables stable genomic integration and gene expression across a range of organ systems. Delivery methods include hydrodynamic tail vein injection, organ electroporation after local injection (e.g., brain, heart), and AAV-piggyBac hybrid approaches.


Synthetic Biotechnology
Super piggyBac is validated for use across a broad range of microbial hosts commonly used in synthetic biology and industrial fermentation. Its ability to deliver large and complex DNA constructs enables the stable insertion of entire biosynthetic pathways, reducing the need for multi-step engineering or selection strategies. This unique capability makes piggyBac an ideal solution for engineering high-value metabolite production strains, such as yeast, bacteria, and filamentous fungi, in both R&D and scalable manufacturing environments.
Agriculture
Super piggyBac is validated for plant genome engineering applications where transient expression and clean excision are critical. It has been demonstrated to stably integrate and seamlessly excise from plant genomes, enabling temporary delivery of gene editing components such as CRISPR/Cas9. This capability supports advanced trait development in crop species while minimizing transgene footprint, offering a valuable tool for precision agriculture and next-generation plant breeding.

Licensing super piggyBac Patented Technology
Hera is the exclusive licensee and sublicensor of this patented technology for drug discovery research, synthetic biotechnology and agriculture.
Optimized Stable Cell Line Development Services
Hera offers expert stable cell line development services optimized for bioproduction of monoclonal antibodies. Our CleanCut™ CHO host platform and advanced gene editing tools deliver high-yield, royalty-free clones ready for scale-up. Learn more on our Cell Line Development page.